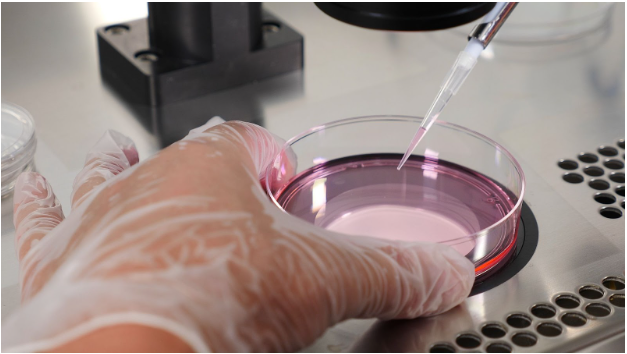
Ovum Pickup Room for IVF – Safe and Advanced Egg Retrieval

At Trinity Women’s Hospital, we know that every step of the fertility journey matters, and precision at each stage increases the chances of success. The Ovum Pickup Room is one of the most critical facilities in the IVF and ICSI process, as it is where mature eggs are carefully retrieved from the ovaries after stimulation. This step plays a vital role in determining the quality of embryos and ultimately, the success rate of IVF treatment.
Our Ovum Pickup Room is designed with state-of-the-art technology, advanced monitoring systems, and a sterile environment to ensure maximum safety and accuracy during the procedure. The entire process is carried out under ultrasound guidance and mild anesthesia, which makes it safe, minimally invasive, and almost painless for the patient.
With strict safety protocols, modern infrastructure, and a team of highly experienced fertility specialists and embryologists, Trinity Women’s Hospital ensures that the ovum pickup procedure is performed with the highest level of care. The retrieved eggs are immediately transferred to our world-class embryology lab, where they are fertilized with sperm through IVF or ICSI, ensuring timely handling and preservation of egg quality.
We understand that fertility treatments can be emotionally and physically challenging. That’s why our focus is not only on clinical excellence but also on providing emotional comfort, patient privacy, and personalized care during the egg retrieval process. By combining advanced medical expertise with compassion, we help couples feel reassured and confident as they take this important step toward achieving their dream of parenthood.
What is Ovum Pickup?

Ovum pickup, also called egg retrieval, is one of the most important steps in the IVF (In-Vitro Fertilization) process. After ovarian stimulation with fertility injections, the ovaries produce multiple mature eggs. These eggs need to be carefully collected to continue the IVF cycle.
The ovum pickup procedure in IVF is performed under ultrasound guidance and mild anesthesia, ensuring that it is both safe and comfortable for the patient. A thin needle is passed through the vaginal wall to gently aspirate the mature eggs from the ovarian follicles. The entire egg retrieval process usually takes 15–30 minutes and does not require a long hospital stay.
Why Choose Trinity Women’s Hospital for Ovum Pickup?
- Advanced Ovum Pickup Room equipped with latest monitoring and surgical tools.
- Experienced fertility specialists and embryologists handling the procedure with precision.
- Strict hygiene and infection control for patient safety
- Comfort-focused care with anesthesia and pain management support.
Seamless coordination with the IVF lab for immediate egg preservation and fertilization.
How Ovum Pickup is Done

Ovarian stimulation with medicines to produce multiple eggs.

Ultrasound-guided retrieval of eggs in the Ovum Pickup Room.
Collected eggs are immediately handed over to the embryology lab for fertilization (IVF/ICSI).

The procedure takes 15–30 minutes, and recovery is quick.
Benefits of Our Ovum Pickup Room
High success rates due to timely and accurate egg collection.
Minimal discomfort and quick recovery for patients.
Safe environment with latest fertility technology.
Fully integrated with our IVF and ICSI programs.
FAQs – Ovum Pickup Room
No, the ovum pickup procedure is performed under mild anesthesia, so patients do not feel pain during the process. At Trinity Women’s Hospital, we prioritize patient comfort, and the procedure is carried out gently by experienced specialists. Afterward, some women may feel slight abdominal discomfort, bloating, or cramping, but this usually lasts only a day or two. Proper rest and hydration help in faster recovery. Since it is a minimally invasive IVF procedure, patients can get back to their normal routine quickly.
The egg retrieval process in IVF usually takes around 15–30 minutes, depending on the number of follicles. At Trinity Women’s Hospital, ovum pickup is performed in a dedicated ovum pickup room under ultrasound guidance for accuracy. Patients are monitored for a few hours post-procedure and can return home the same day. Recovery is smooth, and most women can resume normal activities within 24 hours.
Yes, ovum pickup in IVF is a very safe procedure when performed by trained fertility specialists. At Trinity Women’s Hospital, it is carried out in a sterile environment with advanced monitoring systems, ensuring maximum safety for both the mother and the eggs retrieved. Complications are extremely rare, but we always follow international safety standards to minimize any risks. The use of anesthesia makes it painless and comfortable, and the controlled process ensures high-quality egg collection for IVF success.
After the eggs are retrieved, they are immediately handed over to our embryology lab, where they are fertilized with sperm through IVF or ICSI techniques. The resulting embryos are then cultured in advanced incubators for a few days, allowing specialists to monitor their growth. Once the embryos are ready, the best-quality ones are selected for embryo transfer to the uterus, giving couples the highest chance of pregnancy. Any extra healthy embryos can be frozen for future use through cryopreservation.
A dedicated ovum pickup room is critical for IVF success. At Trinity Women’s Hospital, our Ovum Pickup Room is equipped with modern ultrasound machines, sterile instruments, and real-time monitoring systems to ensure accuracy and safety. The setup allows for the immediate transfer of retrieved eggs to the IVF lab, which is vital for maintaining egg quality. This reduces handling risks and directly improves fertilization and embryo development rates, increasing the overall IVF success rate.
